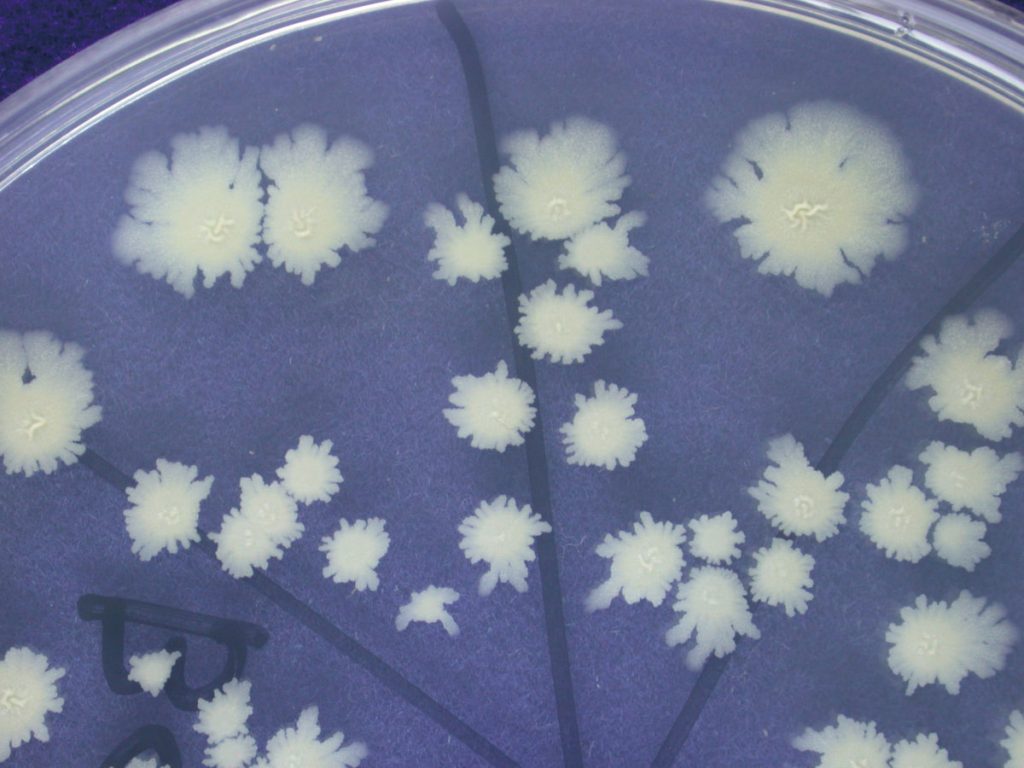
液化澱粉芽孢桿菌（TCB9722）菌落型態。

文‧ 圖╱陳俊位 農業部臺中區農業改良場研究員
在能源危機與極端氣候加劇的當下,農業面臨資源枯竭與生產不穩定的雙重壓力。近年循環農業的發展,將焦點放在如何把這些富含養分的副產物轉化為有效資源,其中以微生物發酵製成的生物性有機液體肥料受到關注。農業部臺中區農業改良場篩選出的液化澱粉芽孢桿菌(TCB9722),結合豆奶粉、海草粉、蝦蟹殼粉與糖蜜等農業剩餘物質,可發酵產出具氮、磷、鉀及多種微量元素的液肥,不僅促進作物生長與提升產量,更能強化抗逆境能力。隨著氣候變遷造成乾旱、淹水與溫度劇烈變化,TCB9722液肥的應用成為協助農民穩定生產的重要突破。
能源危機及資源過度開發造成地球生態系的浩劫,也導致極端氣候問題產生,如何讓資源循環再生利用轉化成可使用資源為現今研究的重點。在農業生產領域中,一般農作生產、畜牧業、養殖業、製油業、釀造製酒業與屠宰業所產生的事業廢棄物極具資源再生的可用性。
臺灣農業生產上每年約產生460~520萬公噸農業剩餘物質,其中以畜產剩餘物質占49%及農產剩餘物質占42%為大宗。這些剩餘物質以掩埋(含就地翻耕)、焚燒、堆肥、製成飼料等處理方式為主。
農產剩餘物質再利用比率約55%。這些剩餘物質如稻桿、蔗渣、稻穀、米糠、粕類、菇類剩餘物質、動物糞便、蝦蟹蚵殼、魚鱗、動物內臟、血水與殘體等皆含有高量的植物性與動物性養分,如能有效轉化這些資源廢棄物成為可再次使用的資源物質,將可減少農業資源的浪費。運用微生物醱酵技術除可將農業廢棄物循環再生利用外,並能運用微生物新科技創造低投入、零污染、高產出及價值高的新循環農業,達到綠色資源永續循環利用。

生物性有機液體肥料 可提升植物生長與產量
目前農友間及部分有機農法會利用含氮量高的農業剩餘物質(如黃豆粕或米糠)配合紅糖與微生物醱酵成液肥,不論微生物的種類為何,與剩餘物質發酵後的產物其實僅是液態有機質肥料,以肥料組成分來看也僅是三要素氮、磷、鉀的組合。微生物液肥發酵配方如能搭配多種農業剩餘物質的養分,則可以開發出適合有機及友善耕作養分需求的功能性微生物製劑配方,養分含量除氮、磷、鉀三要素外,尚有鈣、鎂及多種微量元素,配合可以促進作物根系發育的微生物菌種,可以彌補以往所推廣的單質液態肥配方養分不足或單一元素過量的問題。

生物性有機液體肥料係將菌種結合繁殖資材,配合使用目的,開發出適合各種不同作物使用的產品。液化澱粉芽孢桿菌本身在繁殖過程中即會產生多種代謝產物及衍生物,這些產物包含有供應植物生長的養分、氨基酸、荷爾蒙、抗生素及二次代謝產物等,利用菌種結合農業剩餘物質的營養成分可產出具上述多種成分的產品。
臺中農改場利用所篩選的液化澱粉芽孢桿菌TCB9722,結合豆奶粉、過期奶粉、海草粉、矽藻土、蝦蟹殼粉與製糖剩餘物質糖蜜等農業剩餘資材,組合成多種液肥配方,利用濾袋懸浮式靜置發酵法產製出具促進植物生長、提升產量品質與增加作物抗環境逆境能力的液態功能性微生物製劑。
田間實際應用發現除可促進植物生長提升產量品質外,並能與作物根系共生協助養分吸收,減少病蟲害危害及改善作物生長環境,並有促進作物抗病機制反應產生之能力等功效。

有機液肥製作及應用方法 地面、葉面追肥皆可用
關於製作方法,首先需將乳清蛋白1公斤、海草粉0.5公斤、蝦蟹殼粉150毫升、矽藻土250公克及液化澱粉芽孢桿菌(TCB9722)20公克置入濾袋中,再將濾袋置入塑膠桶中,加入糖蜜2公斤後,加水達8分滿後攪拌使糖蜜溶解均勻。之後將其靜置並加布覆蓋桶口,於每日早上打開攪拌1分鐘,連續14天,14天後,不用再攪拌,繼續加蓋靜置3天。這個過程,前後經14~20天處理後,液體部分即為有機液肥,可直接取用。
本配方成品的養分以磷、鉀、鈣、鎂、矽及微量元素含量較高,施用方法為將稀釋100~200倍的配方於植物地基部澆灌或200~300倍於植物葉面噴灑,3~5天一次,可於植物生長全期及開花結果期施用。


需注意的事項:
一、如使用打氣裝置以增加溶氧量,可以加速分解。
二、液肥完熟程度,除可用外觀(氣泡減少及顏色變暗褐色)、氣味(產生微酸或醬油味)判斷,另可施以種子發芽率檢驗法(用5 0倍稀釋液肥測試,當種子發芽率在80%以上,即可視為完熟)。
三、有機液肥完熟後,最好儲放在陽光無法直射且較陰涼之處,在2~3個月內使用完畢為宜,如儲放過程中,產生極度腐敗臭味,則不宜再使用。
有機液肥的使用原則,在地面追肥方面,使用時加水稀釋100~200倍,每星期使用1~3次,灌注地點以接近根系最多之樹冠範圍較佳,使用量約使地面形成潮溼狀態,讓液肥養分能被作物迅速吸收。而葉面追肥方面,則在使用時加水稀釋200~300倍,每星期可使用1~3次。以噴霧器噴灑,使用量約使葉面形成潮溼狀態,讓液肥養分能被作物迅速吸收,使用前先澆水使地面形成潮溼狀態,吸收效果更加。
針對氣候變遷問題的肥料 開發多種抗逆境的品種與製劑
近年來由於全球暖化及氣候變遷,使得降雨的時間、空間的分布嚴重不均,導致乾旱地區增加或長時間缺水、沿海地區暴雨季節淹水,造成土壤鹽化問題也日趨嚴重,使農作物與動物生產的不穩定性增加。
以往因應氣候變遷,農業科研單位多由品種改良以及栽培等技術與設施加以克服,惟近年氣候變遷更形劇烈,以致災損難以有效降低、穩定生產更為困難。臺中農改場已選育開發出多種抗逆境作物品種與微生物製劑,具有抗淹水、抗乾旱、抗高低溫障礙、提升開花能力及減輕病蟲害等功能。
針對氣候變遷,臺中農改場開發的生物性有機液體肥料,已可有效解決困擾農友多年的栽培問題,在水稻、蔬菜、果樹、花卉及特用作物上已有多種作物使用本技術產品。因應未來栽培環境的惡化、極端氣候的影響、耕作資源的枯竭與病蟲草害的猖獗,相關栽培所使用的加值化微生物製劑與提升作物耐候或抗逆境能力的新穎性應用技術,將是未來應該加強研究與田間應用的重點方向。

